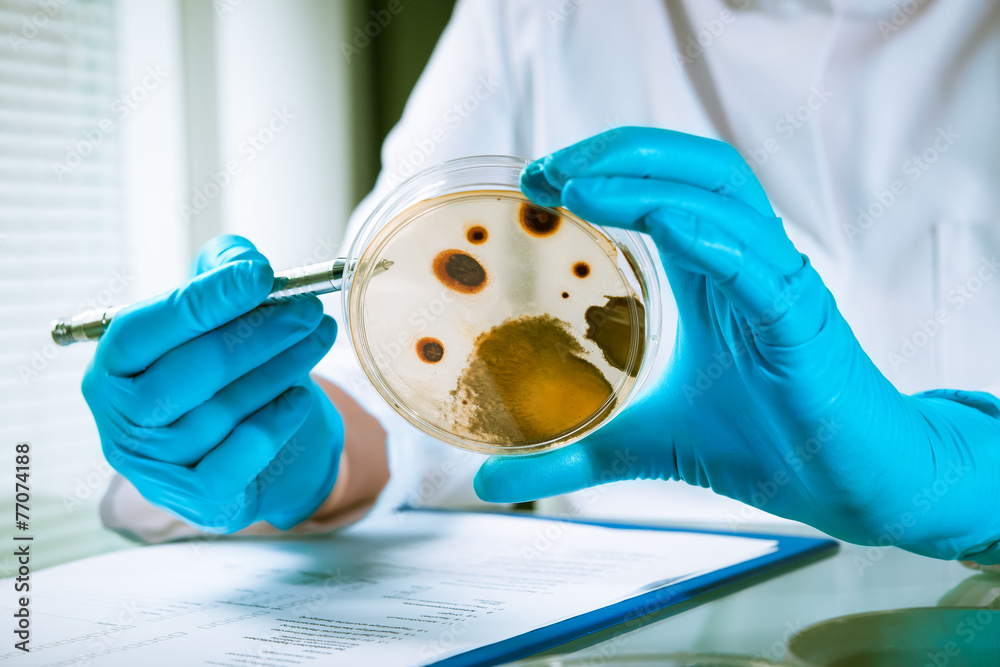

Agar Zum Ausplattieren Der Bakterien
Di: Ava
Bakterien in der Milch Verwenden Sie für Ihre Untersuchungen pasteurisierte Milch und Rohmilch vom Bauern. Legen Sie von beiden Proben jeweils eine vierstufige Verdünnungsreihe in sterilem Wasser (oder besser in 0.9% NaCl) in 1:10-Schritten an. Streichen Sie von jeder Probe 100 µl mit dem Drigalskispatel auf einer Chinablau-Lactose Meistens hat man zumindest eine Vorstellung, in welcher Größenordnung Bakterien in der Ausgangslösung enthalten sind, so dass man sich die Verdünnungsstufen zum Ausplattieren sinnvoll aussuchen kann. Bakterienkulturen können auf verschiedene Art und Weise gezüchtet werden. Setzt man dem flüssigen Nährmedium ein Geliermittel zu und gießt dieses noch heiß in Petrischalen, so erhält man nach dem Abk
Wie man Kolonien in der Mikrobiologie zählt
Grundlegende Methoden, auf die in den Versuchskapiteln verwiesen wird, sind im folgenden Abschnitt des Mikrobiologischen Praktikums aufgeführt. Wo es uns sinnvoll erschien, wurden den eigentlichen „Kochvorschriften“ kurze Erläuterungen zum Prinzip der verwendeten Technik vorangestellt. Neben den in den Versuchen ausdrücklich erwähnten Methoden sind im
Die Keimzahlbestimmung umfasst Methoden wie die Plattenguss-Verfahren, Membranfiltration und die direkte mikroskopische Zählung, um die Anzahl der Mikroorganismen in einer Probe zu ermitteln. Du solltest wissen, dass diese Techniken sowohl in der Lebensmittel- als auch in der Wasseranalyse eine wichtige Rolle spielen. Durch regelmäßige Anwendung kannst Generell kann die Anzucht von Bakterien mit flüssigen, halbfesten sowie festen Nährmedien erfolgen. Dabei werden flüssige Anreicherungsbouillons zumeist als erster Schritt der Kultivierung eingesetzt, um Bakterien, die häufig nur in geringen Mengen vorhanden oder durch die vorherige technologische Behandlung des Lebensmittels subletal geschädigt sind,
Lassen Sie die Agarröhrchen erkalten. Streichen Sie auf dem erstarrten Agar mit der Impföse Ihren zu konservierenden Stammes in einer Zickzacklinie aus.
Einleitung Bakterien sind über die gesamte Entwicklungsgeschichte der Organismen auf diesem Planeten u.a. deswegen so erfolgreich gewesen, weil sie sehr viele Zellen pro Volumeneinheit bilden können. Eine gerade sichtbar getrübte Bakteriensuspension enthält etwa 107 Zellen pro ml. In Zahnplaques, die den Karies verursachen, wurden Zelldichten von über 1011 Zellen pro ml Gleichmäßiger Modus Der „constant“- Modus entpricht einer gleichmäßigen Verteilung auf der Agar-Oberfläche. Sie können 50 µL, 100 µL, 200 µL ausplattieren lassen oder Ihr persönliches Volumen programmieren. Die Auszählung wird erleichtert, da es
- Botanik online: Biologische Übungen 1
- Kultivierungsverfahren für Bakterien
- Mikrobiologische Arbeitsmethoden
Die Schüler züchten die Bakterien normalerweise auf Agar, einer gelartigen Substanz, die die Keime füttert. Mit ein paar einfachen Schritten haben diese Mikroben die beste Chance, auf dem Agar zu wachsen, wodurch das Experiment erfolgreicher wird.
PDF | Lange Zeit war die Isolierung bakterieller pathogener Mikroorganismen mithilfe von entsprechenden Nährmedien die einzige Möglichkeit zum Nachweis | Find, read and cite all the research
Kultivierungsverfahren für Bakterien
Entdecken Sie die Verwendung von Reihenverdünnungen und Ausplattierungsmethoden zur Keimzählung und Quantifizierung der Bakterien- und Viruslast in verschiedenen Umgebungen, wie z. B. klinischen, industriellen, pharmazeutischen und akademischen Labors. Verstehen Sie den Prozess zur Erzielung beherrschbarer Was ist Tellerstreuer? Tellerstreuer normalerweise ist ein zylindrische Stange als Handwerkzeug, das in der Biologie und verwandten Gebieten zum gleichmäßigen Verteilen von Zellen und Bakterien auf Kulturplatten, wie z. B. Petrischalen, verwendet wird. Zellverteiler ist ein grundlegendes Werkzeug für Spreiztechnik in der Mikrobiologie. University of California, Los Angeles. Beim Arbeiten mit und Reagenzien zur Kultur von Mikroorganismen, muss aseptischen Technik praktiziert, um sicherzustellen, Kontamination zu minimieren werden. Eine Vielzahl von Beschichtungsverfahren werden routinemäßig verwendet, um zu isolieren, verbreiten oder aufzuzählen Bakterien und Phagen, die alle
Da es unmöglich ist, alle bekannten Medien und Verfahren zur Kultivierung von Bakterien aufzulisten und zu kommentieren, beschreiben die folgenden Kapiteln bei spielhaft die aerobe Anreicherung und Kultivierung des Sporenbildners Bacillus subtilis, die anaerobe Anreicherung und aerobe Kultivierung von Escherichia coli und ausführ lich die Anreicherung und
Voraussetzungen Eine Minimalforderung für das Autoklavieren ist ein Schnellkochtopf, damit Sie definierte Ausgangsbedingungen für ihre Kulturen herstellen können. Ein Autoklav ist besser, da er mehr Sicherheit liefert. Besorgen Sie sich eine Stammkultur eines „Standard-Bakteriums“. Für den Beginn empfehlen wir E. coli. Das Bakterium können Sie von der DSMZ oder von NUGI
Wie gut ist die Korrelation der Werte zueinander, die Sie einmal durch direktes Zählen und zum anderen durch Ausplattieren gewonnen haben? Wie lang ist die Generationsdauer unter den gegebenen Bedingungen? Kochsches Plattengußverfahren, von R. Koch 1876 in der Bakteriologie eingeführtes Verfahren zur Gewinnung von Reinkulturen und zur
Es ist sehr arbeitsaufwändig, bei Wachstumsexperimenten immer die Bakterien in Verdünnungsreihen auszuplattieren und nach einer längeren Bebrütung die daraus entstehenden Kolonien auszuzählen. Daher wird in der Routine die Anzahl der Bakterien pro Milliliter Kultur aus der Optischen Dichtemessung abgeschätzt. Das Prinzip der spiralförmigen exponentiellen Beschichtung Die Spiral-Plating-Technik ist eine standardisierte Methode der Auszählung durch Ausplattieren, die die Pasteur-Methode vereinheitlicht.
Agarplatten sind Nährbodenplatten. Eine gelatineartige Substanz die aus Algen gewonnen wird (Agar Agar) verleiht der Nährlösung Festigkeit und eine glatte Oberfläche, so wie bei Pudding oder Jelly. Die Bakterien oder Pilze wachsen auf der Oberfläche, und von unten werden sie durch Diffusion mit Nährstoffen versorgt. Erklärung für Kinder: Agarplatten trifft man im Labor am Nach Billiard-Prinzip Forscher und Forscherinnen der Universitäten York und Cambridge in Großbritannien sind die Verteilungsfrage systematisch und physikalisch angegangen, um eine optimale und reproduzierbare Prozedur zum Ausplattieren mit Glaskügelchen zu finden. Dafür nahmen sie ganz normale Petrischalen (88 mm Durchmesser)
Botanik online: Biologische Übungen 1
Nachweis von Mikroorganismen1 Die Durchführung von mikrobiologischen Versuchen zum Nachweis von Mikroorganismen ist für Schülerinnen und Schüler und Schüler besonders motivierend. Für die vorgeschlagenen Experimente ist kein steriles Arbeiten notwendig. Allerdings muss die Handhabung (Abnahme des Deckels der Petrischale beim Beimpfen) geklärt werden. Jedoch ist die Auszählung von Bakterien mit erheblichen systematischen Fehlern behaftet, die zum einen durch die Adsorption der Bakterien an Glassoberflächen, zum anderen durch Schwankungen in dem Zählkammervolumen,
Auswertung des Analyseverfahren für Legionellen: Direktes Ausplattieren (= Direktansatz) von 2 x 0,5ml Wasserprobe auf bestimmten Nährboden ohne Vorbehandlung. Die Koloniezahlen der beiden Direktansätze werden addiert, die Summe mit 100 multipliziert und als 2.6 Anlegen einer Reinkultur / Vereinzelungsausstriche Mikroorganismen kommen überall vor. Sie kommen als gemischte Populationen vor. Veränderungen des normalen Lebensraumes (verändertes Nahungsang
Agarplatten sind ein häufig genutztes Medium in der Mikrobiologie. Dieser Film gibt Hinweise, worauf bei der Herstellung geachtet werden sollte.Englische Ver Es hilft, Petrischalen auf ein Gitter zu legen, um Mikrobenvölker zu zählen. Die häufigsten Mikroben, die Wissenschaftler in Boden, Wasser und Nahrung so Agrobakterien werden heute routinemäßig zur Transformation höherer Pflanzen einge-setzt. Die Pflanzentumor-induzierenden Gene werden dazu aus dem Ti-Plasmid elimi-niert und durch die gewünschten Transgene ersetzt. Die für die Transformation verwen-deten Agrobakterien können keine Pflanzentumoren induzieren.
Agar (aus dem Indonesischen/ Malaiischen), auch Agar-Agar, Agartang, Kanten (japanisch 寒天) oder auch Chinesische bzw. Japanische Gelatine genannt, ist ein Galactose – Polymer (ein Polysaccharid), das Gallerte bilden kann. Das Ausplattieren auf LB-Agar diente der Anzucht von Klonen aus Transformationen. Die Platten wurden zur Anzucht umgekehrt im 37 C Brutschrank f r 18 bis 24 h inkubiert.
- Agbs Asien Special Tours – Asien Special Tours: Indien Themenreisen
- Age Of Empires Iv : Édition Anniversaire
- Aged 45, “Ax Men” Star Craig Rygaard Killed In A Car Crash
- Agents On Stage: Advancing The State Of The Art Of Ai
- Africa: Fdi Stock From China By Country
- Agricultural Simulator 2012: Deluxe Edition
- Agrarhandel Oberland _ Agrarhandel Oberland Gmbh
- Aesthetic Gaming Purple Wallpapers
- Agri-Entrepreneur Platform _ The Best Funding Sources for Agro-Tourism and Rural Entrepreneurship
- Affen Füttern Im Hluhluwe-Imfolozi
- Afi Movie Club: Bridesmaids – "AFI Movie Club" Beanie Feldstein announces Bridesmaids (TV
- Agentur Armin Huspenina : Tierschutzverein Heilbronn und Umgebung e.V.
- Aggregation-Induced Emission: Fundamentals And Applications
- Agriculture Magazine Cover Images